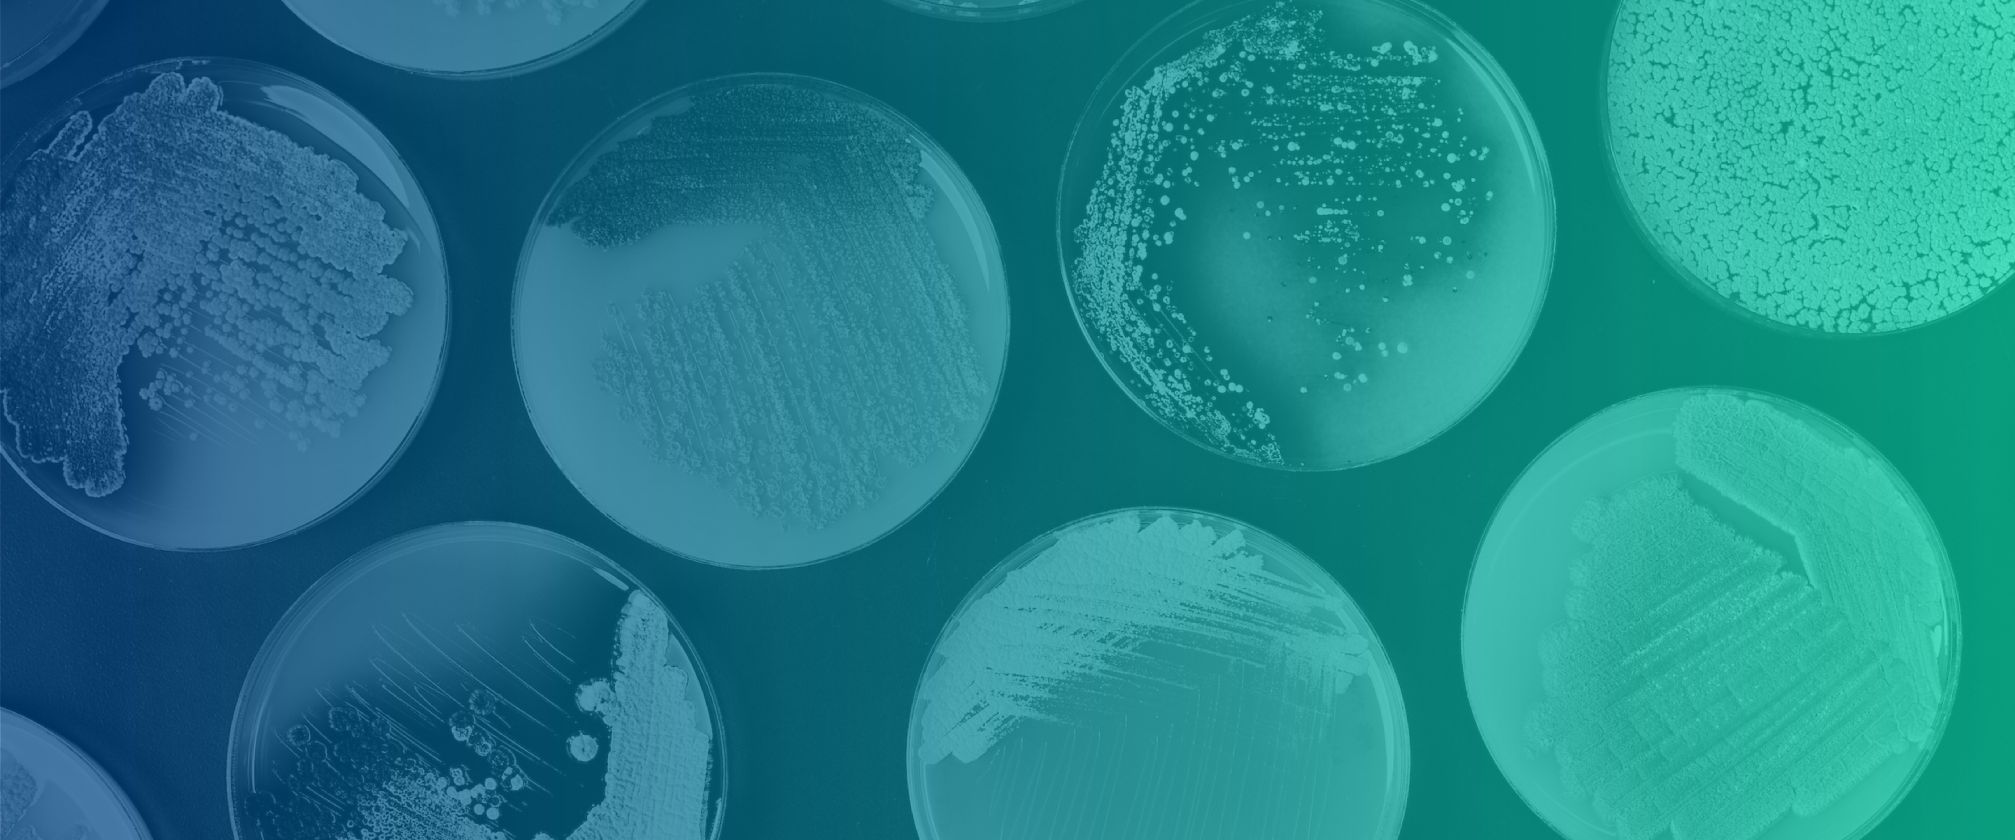

We're Image Conscious Studios
We Bring Life Science Brands to Life.
Your company is making breakthroughs and developing amazing new treatments to improve people’s lives and impact the world around us. You need to attract top talent, investors, and partners as you continue to grow. The designers and strategists at ICS will partner with you to develop a digital brand that tells your story in an engaging, meaningful way, helping you to connect with the right people to keep your organization thriving.
How it WorksGreat folks we've worked with











Ginkgo Bioworks
Our creative digital designers and strategists worked closely with Ginkgo Bioworks’ stakeholders (founders, scientists, designers, and strategists, to name a few) to help build the brand that put synthetic biology on the map and created a whole new category in biotechnology. We started with a quick iteration to meet a tight deadline, and have continued to expand and evolve their digital brand over the years.
Together with the Ginkgo team, we developed the Grow brand, an editorial platform designed to evangelize and celebrate the potential of synthetic biology for the world at large. When Ginkgo quickly responded COVID by launching and scaling Concentric, we partnered with them to bring a new digital brand to market as fast as possible through our collaborative and iterative design and development strategy.

Grow by Ginkgo


Sapient
How do you create a digital experience that will make users believe what they had thought was impossible? That’s what we set out to do for Sapient—a biotechnology company that leverages the power of mass spectrometry with massive data sets and actionable health insights across the drug discovery and development spectrum. ICS built a simple and elegant user experience to convey the company’s expertise with complex data at scale. We deployed interactive elements to engage users and encourage a deeper understanding of Sapient’s value proposition. We deployed animation and motion strategically to show rather than tell the story and avoided details that did not serve a greater purpose. The result is a sleek and polished experience befitting a technology-forward industry leader.




Elevation Oncology
Elevation Oncology is purpose built to illuminate the path forward for cancer treatment through precision therapies that make genomic testing actionable for every patient. Elevation Oncology’s strong commitment to the mission translates into a strong visual style. We partnered with them to create a visually engaging experience for the brand and a foundation for future scale and growth. The site uses motion elements and visual polish to enhance and strengthen Elevation Oncology’s core messaging and mission. It also serves as a platform for building a collaborative landscape in oncology, particularly around NRG1, that includes resources, blogs, thought-leadership and dialogue with the scientific community. The ICS team created a corporate style guide and full suite of collateral from business cards to print and digital ads and social assets. We even got to create a Nasdaq tower animation!







Selecta Biosciences
Selecta Biosciences is revolutionizing biologic therapies to expand treatment options for patients with serious and debilitating diseases. They partnered with us to evolve their brand to better communicate and visually express their story to potential investors, KOLs, and recruits in a very crowded market. Their technology is complex but the end goal is very simple: leave a lasting legacy of improved care for patients.
So, we focused on developing a visual language that balances human-centric imagery with scientific imagery to connect Selecta’s science and technology with real people and real outcomes. The result is a dynamic brand that highlights the cutting-edge nature of the technology and how that technology impacts people’s lives for the better.





Octant
Octant came to us with a challenge: how can we partner together to showcase Octant’s powerful but hard-to-explain technology through their brand and digital experience? And how can we present the company as fresh, cutting-edge—and importantly fun—without alienating their highly-educated core users?
Our discovery work surfaced throughlines that inspired our designers and strategists. Courage is at the heart of Octant. The company’s foundation is built on taking risks that others aren’t willing to take. We paired the idea of courage with their inspired name, Octant. This intentional reference to mapping the unknown aligns Octant’s core science and technology and their approach to company culture. The brand expression of these themes creates an exciting and energetic digital experience.





Akouos
Akouos develops gene therapies with the potential to restore, improve, and preserve high-acuity physiologic hearing for people who live with disabling hearing loss. They serve a wide spectrum of audiences—patients, investors, clinicians, advocates, and more, through three flagship points of entry: the Akouos website, the Sing Registry (a global longitudinal observational study), and Resonate (a program to improve genetic testing). ICS was challenged to create and build a brand that allows each separate digital experience to stand on its own but also tie back to the Akouos brand as a whole. We used color and repeating visual motifs to connect each digital space while creating a custom look and feel for each.





Sing Registry



Resonate by Akouos

Abata Therapeutics
When we began our partnership with Abata Therapeutics, the company was just coming out of stealth mode with its new approach to the treatment of autoimmune disease by engineering Tregs. Our discovery work surfaced two important themes that we kept front and center as we developed the brand. First, Abata’s story is centered around people. While science is core to what Abata does, its mission is to make life better for patients who don’t currently have any effective therapies available to them. Our designers expressed this mission through visuals that feature human-centric imagery over clinical scientific images. We also knew that Abata would be launching in a crowded and competitive space and our task was to design a brand that would stand out. Here we leaned on the translation of Abata as “tranquil” or “a place of peace.” Every design choice was made to support a calm, human, and welcoming visual narrative—in contrast to a tech-heavy approach commonly seen in the competitive landscape.
Abata’s challenge was not only brand focused. Our development team built a website that will flex and grow as the company advances their programs to clinical trials and then to market. The site’s modular, flexible UI and backend dev systems support an ever changing, ever growing company.







Get in Touch
Let's start the conversation today.
Please fill out this form to set up a no-pressure consultation to explore a creative partnership with ICS.




